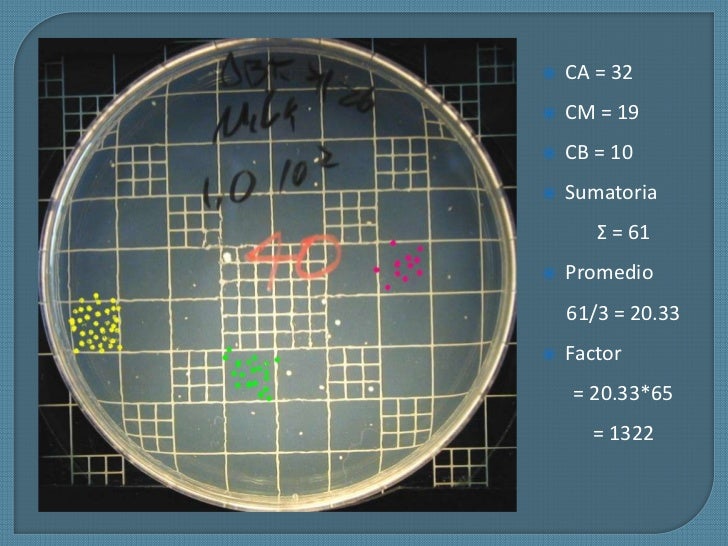

Cultivo de
microorganismos

Nutrición
y
medios de cultivo
Nutrición microbiana
Nutrientes → Elaboración
de componentes celulares
Crecimiento microbianox
Más del 95 % del peso seco de la
célula microbiana está constituido por
unos pocos elementos:

C, O,H, N,S,P,K,Ca, Mg,Fe
El 5% restante corresponde a
los elementos traza:
Mn,Zn,Co, Mo,Ni,Cu


Factores de crecimiento
Son compuestos orgánicos que se necesitan en muy pequeñas cantidades, sólo por algunas células
Son denominados como:
Protótrofo
Generalmente porque el microorganismo
no es capaz de sintetizarlo
Bebe suministrarse
en un medio de cultivo
Son denominados como:
Auxótrofo

Estos son:
Vitaminas,
Aminoácidos,
Bases nitrogenadas
Medios de
cultivo
Es una preparación líquida o
sólida utilizada para el crecimiento, transporte, o
mantenimiento de microorganismos
Para el cultivo correcto de un microorganismo determinado es necesario conocer:
Sus exigencias nutricionales
y ademas que tanto necesitan
Los nutrientes en exceso pueden
inhibir el crecimiento o resultar tóxicos

Importancia del
pH
Debe haber un valor adecuado de pH que
permita iniciar el crecimiento y que no limite la
etapa posterior de desarrollo
Para evitar cambios bruscos de pH
Uso de amortiguadores
(Buffer)

Clasificación de lo
medios de cultivo

Por su composición
Sintéticos / químicamente definidos
Alto grado de pureza
Elaboración minuciosa
Complejos
Ingredientes de naturaleza compleja
Extractos de tejidos animales o vegetales
Cultivos de tejidos (riñón, pulmón, embriones de pollo)
Por su estado
físico
Líquidos
Hacer diluciones
Rehidratar
Enriquecer cultivos

Sólidos
Separar moos → desarrollo de colonias aisladas
Medio líquido + agente solidificante
1.5% a 2% de agar
Semi-sólidos
Determinaciones de movilidad
0.4% a 0.8% de agar
Por su
aplicación

Selectivos
Favorecen el desarrollo de un moo específico
y suprimen el crecimiento de otros
Ejemplos: MSA, EMB, MacConkey

Diferenciales
Sustancias nutritivas o indicadores que permiten
poner de manifiesto alguna actividad metabólica
de un moo
Ejemplos: MSA, EMB, MacConkey, Agar sangre

Enriquecidos
Permiten el desarrollo de moos exigentes
Son químicamente complejos o ricos en nutrientes
Ejemplo: Agar sangre
Para cuantificación
de bacterias
Cantidad de moos, calidad
microbiológica de agua, leche, etc.
De valoración /
de prueba
Efecto de antibióticos / desinfectantes
Vitaminas y aminoácidos
De mantenimiento /
transporte
Preservar la viabilidad de las células al ser
transportadas al sitio del estudio.

Condiciones de
incubación
Control de oxígeno en
los cultivos microbianos
Los microorganismos aerobios estrictos
crecen sobre la superficie de placas
de agar y en la parte superior de
medios líquidos.
Pero si se quiere obtener organismos
aerobios en grandes cantidades se
debe incrementar la exposición del
medio a la atmósfera

Para esto puede
haber 2 modos:
Aumentando la ventilación por agitación
constante del medio líquido inoculado
Introduciendo aire estéril en el medio
Para las bacterias
anaerobias estrictas
Se utiliza medios reductores como cistina, tioglicolato o Na2S.
Para cultivo sólido
de bacterias anaerobias
Se utilizan jarras de
anaerobiosis

Prueba de pureza
y conservación

Prueba de pureza
Después de aplicar técnicas de
"aislamiento" al microorganismo
de interés
Esto garantiza
el "aislamiento"
Observación de características:
Macroscópicas
Morfología colonial
Microscópicas
Morfología, agrupación,
Gram, etc.
Técnicas de
conservación
A corto plazo
Una vez "aislado" → siembra en 2 tubos
Trabajo
Reserva
Resiembras periódicas
Guardar en refrigeración
A largo plazo
Congelación
Liofilización

Colecciones
de cultivos
Cepario
“Biblioteca de microorganismos”
Identificación de sus características
genotípicas y fenotípicas
Cepa
Conjunto de microorganismos
que derivan de progenitores bien
definidos
Poseen una dotación genética simila
r y conservan ciertas
características por
generaciones

Colecciones
de cultivos
Microorganismos y líneas celulares de referencia
Adquisición, autentificación, reproducción, preservación,distribución y desarrollo

Técnicas de siembra
de microorganismos

Cultivo
Un cultivo de microorganismos es una población
microbiana obtenida en el laboratorio, bajo
condiciones controladas
Cultivo de
microorganismos
2 Tipos:
Cultivo puro
Sólo existe un tipo
de microorganismo
Para obtener un cultivo puro a
partir de una muestra de un
ambiente natural es necesario
aplicar "técnicas de aislamiento"

Cultivo mixto
Varios tipos
de microorganismos

Colonia
Es una agrupación de bacterias formada a
partir de la reproducción de una Unidad Formadora de
Colonia (UFC) sobre un medio sólido

Una UFC puede ser un solo
microorganismo o bien un grupo de
microorganismos de una misma especie
Características:
Subtopic

Morfología
Tamaño
Esta característica es bastante constante dentro de las especies y puede ir desde colonias muy diminutas hasta un diámetro de varios milímetros.
Forma
Está determinada por su borde y su espesor.

Consistencia
y textura
La consistencia de las colonias puede variar desde una colonia seca que puede moverse sobre el agar con el as.
Hasta una colonia viscosa que
se pega al asa y forma filamentos o hilos mucosos cuando se trata de separarla del agar.
Superficie
Puede ser uniformemente brillante y suave o puede ser estriada con muescas concéntricas o quebradas.
Pigmentación
Esta característica es muy común en las bacterias saprófitas en las que las colonias aparecen rojas, anaranjadas, amarillas, etc.
El pigmento no se aprecia en las
células individuales a que se debe a gránulos intracelulares muy pequeños para verse
con luz transmitida.

Técnica
aséptica
Método o procedimiento para evitar que los gérmenes infecten una cosa o un lugar
Sigue una
serie de recomendaciones
de seguridad
para llevarse acabo:
Limpieza de la zona de trabajo / manos
Trabajo dentro de la "Zona aséptica"
(cerca de la flama)
Utilización de instrumentos para
transferencia estériles
Utilización de medios
de cultivo estériles
Instrumentos para transferencia
de microorganismos
Pipeta Pasteur, serológica y la automática
Asa bacteriológica, micológicay aguja
Técnicas de
siembra
Siembra en
medio líquido
Consta de una serie de pasos
para llevarse a cabo
Se puede resumir
de la siguiente forma:
Tipo de
muestra de
procedencia
Tipo de medio
Preparaciones previas
Instrumento
detransferencia
Depende del tipo de
muestra y del objetivo
de la siembra
Objetivo de
la siembra
Considerar la
presentación del
medio líquido
Siembra en
medio sólido
Consta de una serie de pasos
para llevarse a cabo
Se puede resumir
de la siguiente forma:
Tipo de
muestra de
procedencia
Tipo de medio
Preparaciones previas
Instrumento
detransferencia
Depende del tipo de
muestra y del objetivo
de la siembra
Objetivo de
la siembra
Considerar la
presentación del
medio líquido

Técnicas de
aislamiento:
Por separación física
Medio líquido
diluciones
Por agotamiento de un pequeño
inóculo en un medio de cultivo sólido
Diferentes técnicas
de siembra
Mediante la utilización de medios
de cultivo selectivos
Contienen alguna sustancia que inhibe a algunos
μoos pero no afecta el crecimiento del μoo que se desea estudiar
Aprovechamiento de características
particulares de algún μoo
Formación de esporas, anaerobio,
sustratos poco comunes
Técnicas para favorecer
crecimiento

Patrones de estriado que
favorecen crecimiento masivo
Estría recta
Estría en
cuadrantes
Estría en
cuadrante radial
Estría cruzada
Instrumentos de siembra
Asa bacteriológica, hisopo
Técnicas para
favorecer crecimiento
Esta consiste en el uso
de un agar inclinado
Puede ser por:

Picadura

Estriado simple

Siembra en
medio semi-sólido
Es usado
principalmente para:
Pruebas bioquímicas
Determinación
de movilidad
Si la movilidad es
positiva habrá turbidez
difusa en el medio
Crecimiento solo
en el sitio de punción